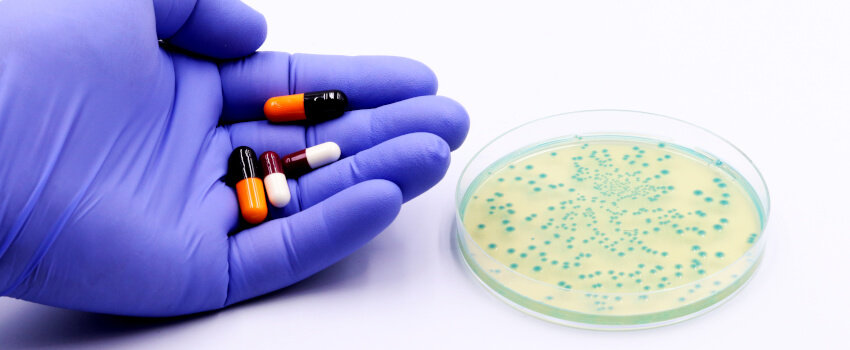
antibiotics and bacteria

An “exciting” new antibiotic that targets deadly gram-negative superbugs has achieved promising results in Phase I clinical trials.
Researchers at Monash University in Australia think QPX9003 – a synthetic lipopeptide developed from a polymyxin B scaffold – could be the first significant drug of its type in more than 60 years.
The Phase I human trials confirm the results of a March study by the Melbourne-based group, which demonstrated QPX9003’s superior safety and efficacy against “top-priority” multidrug resistant (MDR) pathogens, compared to its predecessors.
Data from the new trials showed that QPX9003 was well tolerated in single dose escalation up to 400 mg, and multiple doses up to 600 mg per day for 14 days, with no nephrotoxicity or significant adverse effects observed. Also encouragingly, none of the healthy adult participants recruited for the testing had to withdraw.
The human trial results are particularly intriguing because, in murine testing carried out at Monash, QPX9003 achieved bacterial killing of P. aeruginosa, A. baumannii, and K. pneumoniae – the World Health Organisation’s top three pathogen targets for antibiotic drug development.
Amid the “major global health crisis” presented by antimicrobial resistance (AMR), those three MDR pathogens are major causes of morbidity and mortality from hospital-acquired and ventilator-associated pneumonias.
Another reason that QPX9003 could be particularly significant is the current “dry development pipeline for new antibiotics” that has compelled clinicians to turn to problematic polymyxin B and colistin in an attempt to circumvent AMR.
As the Monash group points out, polymyxin antibiotics were first discovered in the 1940s and introduced into clinical settings in the late 1950s – but no new drugs of their class have been approved in over 60 years.
There are also significant drawbacks to treating patients with polymyxin B and colistin – including nephrotoxicity, which affects up to 60 per cent of people given the drugs intravenously and severely limits the available treatment window. This acute toxicity also restricts the maximal dose that clinicians can prescribe – while the fact that the drugs are manufactured by fermentation can also affect product quality.
Another major issue with these venerable existing treatments is that they are ineffective against pulmonary infection. But the Monash study published in March demonstrated “efficacy against lung infections compared to polymyxin B and colistin” - as well as “a wider therapeutic window, reduced nephrotoxicity and acute toxicity, (plus) improved drug exposure.”
The Monash group said the potential breakthrough that QPX9003 represents is based on “a different strategy for the discovery of new polymyxin lipopeptides” – involving “systematically modifying multiple positions throughout the polymyxin scaffold, while optimizing for multiple parameters” (e.g. antibacterial activity and nephrotoxicity).
“This is the first time that positions 6 and 7 in the polymyxin scaffold have been specifically targeted to modulate their pharmacological properties,” they added.
“As a result, we identified several new structural hotspots driving antimicrobial activity (positions 6 and 7), nephrotoxicity (positions 3, 6, and 7), acute toxicity (N-terminal fatty-acyl group), and lung surfactant binding (N-terminus and position 7).
“Optimizing the combination of modifications at all the positions targeted… was critical for providing lipopeptides with the best balance between potency and toxicity.
“Importantly, for the first time, we have been able to structurally disconnect the antimicrobial activity from nephrotoxicity, acute toxicity, and lung surfactant binding to develop a synthetic lipopeptide that is pharmacologically distinct from the existing polymyxin drugs.”
The head of Monash’s antibiotic drug discovery programme, Professor Jian Li, described the positive Phase I results as “inspiring” - and “critical” in the search for the development of safer higher-dosage antibiotics.
Michael Dudley, the chief executive officer of Monash’s commercial partner Qpex Biopharma, added: “It is exciting to see the progress of QPX9003 advancing.
"QPX9003 has the potential to provide a new treatment option for patients with drug-resistant infections for which there are limited treatment options.
“We look forward to discussions with regulators on the next steps toward studies in patients.”
TRC and ATCC – for all your research chemical and drug discovery needs TRC has more than 40 years’ experience working through some of the most complex synthetic pathways to deliver you high quality research chemicals. Our world-leading chemists engineer specific solutions for customers, and we have a uniquely large range - including many novel bioactive molecules for research into infectious diseases, such as antivirals, antibacterials and antiparasitics. The TRC portfolio contains the tools you need to fight antimicrobial resistance -and features 12 antibacterial drug classes, from macrolides to carbapenems, as well as antifungals and antimycobacterials.
ATCC microbe strains were used in this study. The ATCC biorepository contains the world’s largest collection of microbial reference strains, authenticated with advanced genotypic, phenotypic and functional analysis.
|